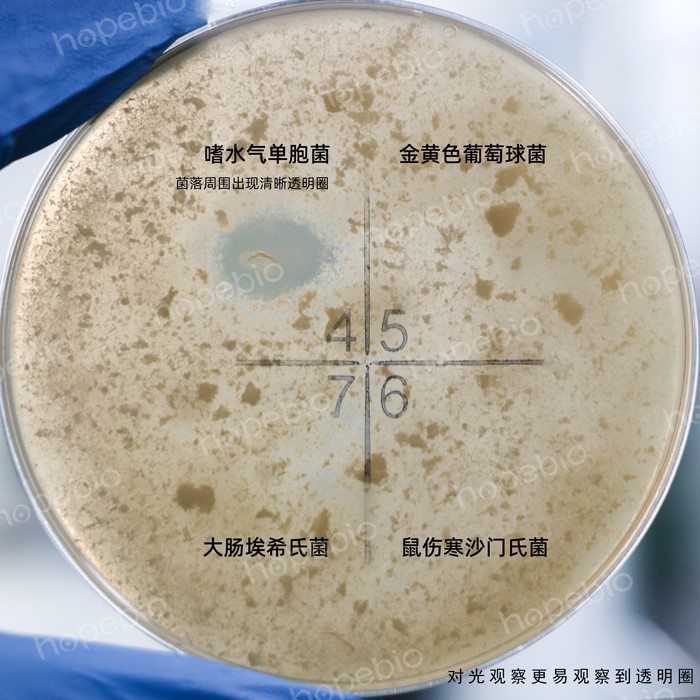

海博微信公众号
海博微信公众号
 海博天猫旗舰店
海博天猫旗舰店


 海博微信公众号
海博微信公众号
 海博天猫旗舰店
海博天猫旗舰店




在水产养殖业蓬勃发展的当下,弧菌作为一种常见的致病菌,给行业带来了诸多困扰。它们广泛存在于海洋、淡水等水体环境中,当水产养殖环境发生变化或养殖生物自身抵抗力下降时,弧菌便会趁虚而入,引发多种疾病,导致养殖生物大量死亡,给养殖户造成巨大的经济损失。
一、不同种类弧菌对各类水产产品的影响
弧菌的种类繁多,不同种类的弧菌对各类水产产品的影响也存在差异。
1.副溶血性弧菌
副溶血性弧菌是海水养殖中常见的致病菌之一,对虾类(如南美白对虾、斑节对虾、罗氏沼虾等)的危害尤为严重,是引起对虾急性肝胰坏死病(AHPND)的主要病原,严重时可达100%的死亡率,是影响全球对虾养殖的重要疾病之一。当对虾感染该弧菌后,会出现空肠空胃、肝胰腺肿大变色等症状,发病急、死亡率高,常常在短时间内给虾类养殖带来毁灭性打击。同时,副溶血性弧菌也会感染贝类,如牡蛎、扇贝等,导致贝类出现死亡现象,影响贝类的品质和产量。
副溶血性弧菌的革兰氏染色镜检图如图1所示,副溶血性弧菌为革兰氏阴性多形态杆菌或弯曲弧菌,(0.5~0.8) um×(1.4~2.6) um,无荚膜,无芽胞,有极生鞭毛(在液体培养基中形成一端单鞭毛,在固体培养基上可能出现周生鞭毛),具有嗜盐性,最适氯化钠浓度为35 g/L,无盐培养基中不能生长。最适温度为37℃,最适pH为7.7~8.0,但pH 9.5时仍能生长。37℃培养18 h-24 h后,菌落呈圆形、微凸、光滑湿润、无色、半透明、边缘整齐,直径约2 mm~3 mm。致病性较强的菌株在含高盐甘露醇的兔血和人О型血的琼脂平板上产生β溶血(神奈川现象)。

图1 副溶血性弧菌ATCC 17802的革兰氏染色镜检图
2.溶藻弧菌
溶藻弧菌(如图2所示)同样对海水养殖生物威胁较大,它可感染鱼类,像大黄鱼、石斑鱼等。受感染的鱼类会表现出体表出血、鳃部腐烂、腹水等症状,生长速度减缓,抗病能力下降,最终大量死亡。此外,溶藻弧菌还会侵袭甲壳类动物,如螃蟹,使螃蟹出现烂肢、甲壳溃疡等问题,降低其商品价值。溶藻弧菌通常被认为是条件致病菌,在海水和海产品中大量存在,致病力弱,达到一定数量才可发病。

图2 溶藻弧菌CMCC 20100及副溶血性弧菌ATCC 17802
在弧菌显色培养基(第二代)上的菌落特征
3.嗜水气单胞菌
嗜水气单胞菌属于弧菌科气单胞菌属(如图3所示),是水产养殖中危害极大的病害菌,可使鱼类感染疾病,进而导致鱼类的大量死亡。嗜水气单胞菌侵入鱼体后,先在肠道内增殖,再经门动脉循环进入肝脏、肾脏及其他组织,引起肝脏、肾脏等器官以及血液病变,继而出现全身症状。由嗜水气单胞菌感染的疾病一般病势较猛,多为恶性传染病,死亡率很高。
图3 嗜水气单胞菌、金黄色葡萄球菌、大肠埃希氏菌、鼠伤寒沙门氏菌在脱脂奶蔗糖胰蛋白胨琼脂上的菌落特征;嗜水气单胞菌菌落周围出现清晰透明圈
4.哈维氏弧菌
哈维氏弧菌(Vibrio harveyi)是多种水产养殖动物的一种主要的病原弧菌,广泛分布于养殖海水和水产动物的体内外,是发光的海洋细菌。通常苗期动物和动物幼体常被感染,对虾幼体阶段时感染哈维氏弧菌死亡率几乎达到100%。
5.霍乱弧菌
霍乱弧菌(如图4所示)虽然主要以人类为宿主,但在水产养殖中也会对某些水产动物造成影响,例如淡水鱼类中的鲢鱼、草鱼等。感染后的鱼类会出现肠道炎症、腹泻等症状,影响其正常生长和发育。

图4 非O1群霍乱弧菌在四号琼脂平板上的生长情况:
菌落扁平湿润,中心黑色,直径2 mm-3 mm。
二、水产养殖中弧菌的防治方法
面对弧菌带来的危害,采取有效的防治方法至关重要。
1.预防方面
首先要做好养殖环境的管理。定期对养殖水体进行检测和消毒,可采用生石灰、漂白粉等消毒剂,降低水体中弧菌的数量。合理控制养殖密度,避免过度养殖导致水体环境恶化,为弧菌的滋生创造条件。其次,加强苗种的检疫工作,选择健康无病的苗种进行投放,从源头上减少弧菌的引入。另外,科学投喂也是预防弧菌感染的重要措施,保证饲料的营养均衡,增强养殖生物的抵抗力。可在饲料中添加一些益生菌、免疫促进剂等,提高养殖生物的免疫力和抗病能力。
2.治理方面
当发现养殖生物感染弧菌后,要及时采取措施进行治疗。可根据病情的严重程度和养殖生物的种类,选择合适的抗生素进行治疗,如土霉素、氟苯尼考等。但要注意合理使用抗生素,避免滥用导致弧菌产生耐药性。同时,也可采用一些生物防治方法,如投放有益微生物,利用其与弧菌竞争营养和生存空间,抑制弧菌的生长繁殖。此外,对于发病严重的养殖池塘,要及时将病鱼、病虾等捞出进行处理,防止病情扩散蔓延,并对池塘进行彻底的清塘消毒,消除弧菌的滋生环境。
3.噬菌体防治弧菌
随着抗生素的研发与广泛应用,养殖户普遍采用抗生素防治水产养殖中的病害,导致养殖生物体内耐药菌株不断积累,耐药性持续增强。这一现象不仅降低了病害防治效果,还加剧了环境污染,破坏了水生生态平衡,甚至通过食物链传递影响人类健康。相比之下,噬菌体制剂作为一种具有高度特异性的生物防控手段,能够精准裂解目标病原菌,且不易诱导养殖生物产生耐药性。此外,噬菌体还具有环境兼容性好、残留风险低、不破坏水体微生态等优势,显示出广阔的应用前景和可持续性价值。
总之,弧菌对水产养殖业的影响不容忽视,养殖户需要充分认识到弧菌的危害,采取有效的预防和治理措施,降低弧菌感染的风险,保障水产养殖业的健康发展。
本公司有培养以上菌种的相关培养基,见表1。更多培养基产品详情请见青岛海博生物官方网站
表1 青岛海博生物相关产品信息
|
产品编号 |
产品名称 |
规格 |
产品说明及用途 |
|
HB4131 |
250g |
用于副溶血性弧菌选择性增菌培养,用前应无菌加入多粘菌素B(SN标准) |
|
|
HB4143 |
250g |
用于副溶血性弧菌的选择性分离培养(GB标准) |
|
|
HB4144 |
250g |
用于副溶血性弧菌的溶血试验(GB标准) |
|
|
HB7011-5 |
1000mL |
用于弧菌的显色培养,副溶血性弧菌显蓝绿色, 霍乱弧菌和创伤弧菌显紫红色, 溶藻弧菌显淡黄色或米黄色 |
|
|
GS013 |
20支 |
用于副溶血性弧菌生化鉴定 |
|
|
HBJZ120 |
支 |
主要用于阳性对照反应和培养基质量控制等实验 |
|
|
HB8634 |
250g |
用于致病性嗜水气单胞菌的鉴别培养 |
|
|
GB173 |
20支/盒 |
用于嗜水气单胞菌的鉴定 |
|
|
HB4129-9 |
250g |
用于致病性嗜水气单胞菌增菌培养 |
|
|
HB4133-2 |
250g |
用于霍乱弧菌的分离培养(GB标准) |
|
|
HB5203 |
250g |
用于分离培养霍乱弧菌,麦迪霉素检定用 (中国药典) |
|
|
SN032 |
20支 |
用于霍乱弧菌生化鉴定 |
注:本文属海博生物原创,未经允许不得转载。
上一篇:微生物发酵在各领域中的应用
下一篇:没有了!
| 相关文章: | ||



